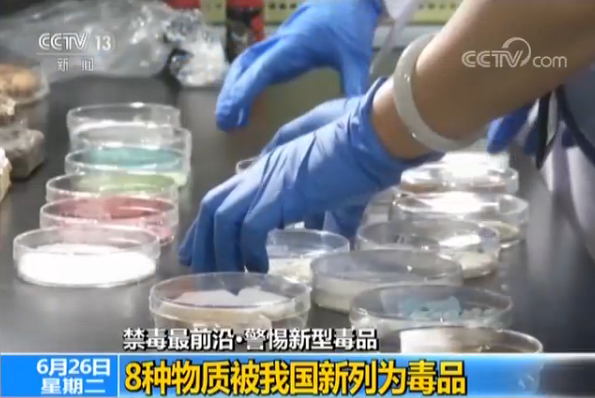

全国现有吸毒人员255.3万人
今天(26日)是国际禁毒日。今年我国的宣传主题是“健康人生、绿色无毒”。

昨天发布的《2017年中国毒品形势报告》数据显示,截至2017年底,全国现有吸毒人员255.3万名,占全国人口总数的0.18%,远低于一些欧美和东南亚国家。但值得注意的问题是,毒品滥用问题总体仍呈蔓延之势,从毒品滥用种类看,仍以冰毒、氯胺酮等新型毒品为主。其中,滥用冰毒144万名,占56.4%,滥用氯胺酮8.5万名,占3.3%。
8种物质被我国新列为毒品
针对新型毒品犯罪日趋严重的情况,2017年,我国又将8种物质新列入了非药用麻醉药品和精神药品目录,予以管制,这也就意味着这8种物质在法律意义上成为了毒品。

这八种物质有6种是合成阿片类物质,包括4种芬太尼类似物及U-47700和MT-45,此外还有2种精神兴奋药物PMMA和4,4’-DMAR。专家解释,它们都属于化学合成的新型毒品。


公安部国家禁毒实验室 花镇东博士:这八种物质因为都属于合成毒品,从它刚刚生产出来的状态来看,应该都是白色的粉末,有时候可能不太纯发一点棕色,发一点灰色就是这样的状态,产品就是这样的形态,但是最终它们进入消费者使用的过程当中,还会进行一些加工处理,比如说压制成一些药片,还有的像芬太尼类的物质,很常见的就是和海洛因这样一些很传统的毒品,把它混合在一起进行使用,以增加它们的药效。
花镇东博士介绍,这八种新型毒品,都是属于新精神活性物质,也被称为第三代毒品,其毒理作用比传统的海洛因、吗啡更加强烈,比如被我国新列入管制的卡芬太尼,成人的致死量只为约2毫克。据了解,2000年之后,全世界范围内监测到的新精神活性物质已经达到了八百多种,我国也在随时监测,不断地将一些新物质列入管制之列。
新型毒品形态更多样 危害更大

专家介绍,毒品换代的速度越来越快,第一代毒品大都是从植物中直接提取,比如鸦片膏、海洛因、有致幻作用的毒蘑菇等,第二代毒品出现在上世纪六七十年代,以化学合成的K粉、冰毒为主。第三代毒品主要是指2000年之后出现的新型毒品,主要是化学合成的新精神活性物质。

专家介绍,为了逃避打击,第三代毒品更新换代速度更快,两三年就可能会出新品种,形态也更为多样,比如可以渗入饼干、烟丝、香草、饮料中,更易于让人受到蒙蔽。




评论